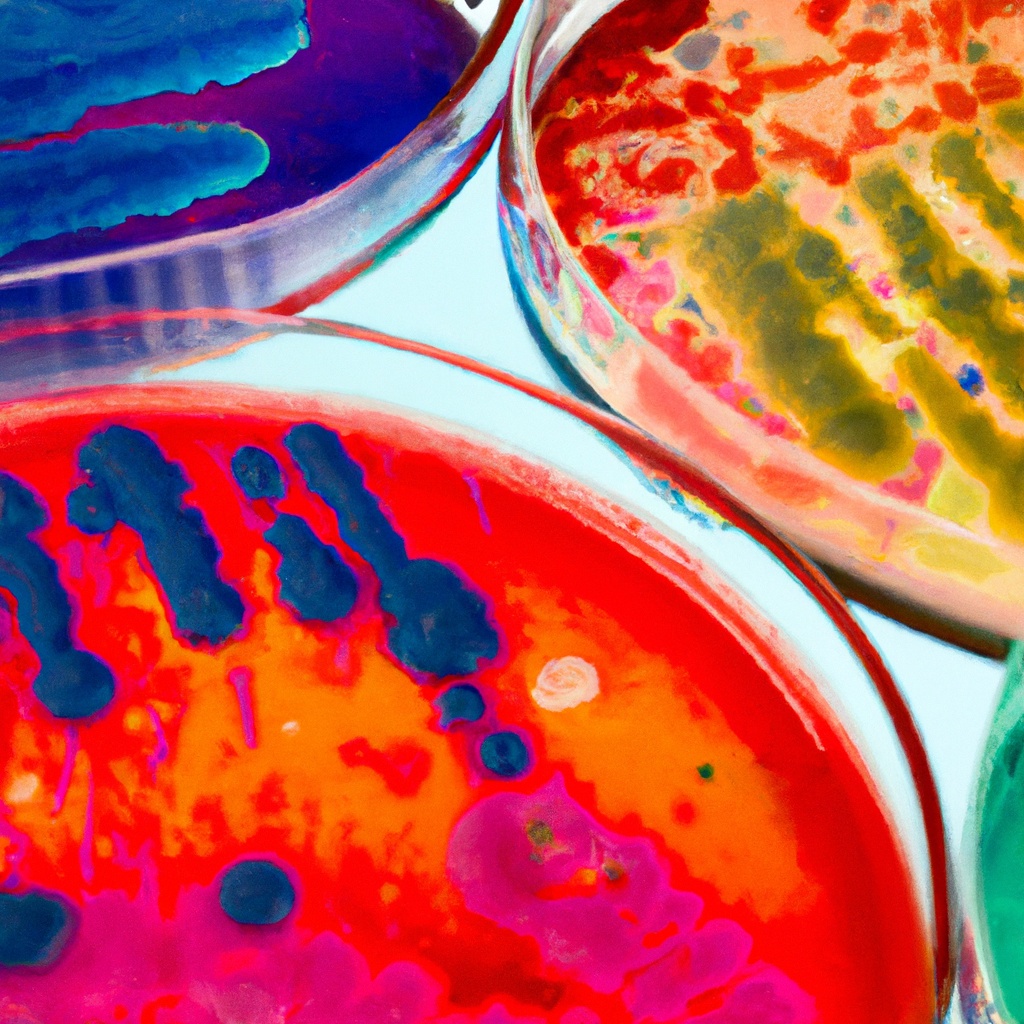

I
f you are a college student struggling with the many concepts, chemistry and cell details behind microbiology, these classes are for you. They are engaging, relevant and concise. You can learn in small pieces as you go. See how the prokaryotes are unique and very strong little cells.
I will take you through several modules, including a chemistry review. There is plenty to memorize, and some tips for memorizing will be given.
Concepts include gram negative, gram positive, different types of specialized stains,accessory organelles and metabolism, with emphasis on aerobic and anaerobic respiration modes, some laboratory techniques will also be discussed.